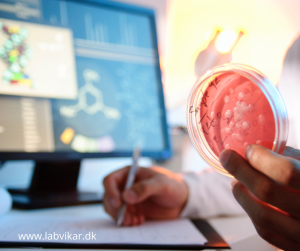

BESAT: LabVikars trofaste kunde har brug for en kandidat med 1-3 års erfaring fra laboratorium, der udfører rutinemæssige mikrobiologiske analyser (totalkim, coliforme, gær/skimmel).
Erfaring inden for fødevarebranchen eller fødevarerelaterede virksomheder ses som en fordel. Men god erfaring med mikrobiologiske analyser er det primære. Rette vikar er kvalitetsbevidst, vedholdende samt struktureret med sine opgaver.
LabVikars kunde er beliggende knap 20 km nordøst for Aarhus, og har brug for en vikar hurtigst muligt. Planen kunne være oplæring i uge 22 – 28 (mandage + tirsdage kl. 9.00-15.00) med mikrobiologiske analyser på råvarer, færdigvarer og produktionsmiljø.
Derefter aftaler kunde og kandidat selv om der skal være tale om 2 eller 3 dage om ugen. Det er en fortløbende opgave, der kan variere i tid og omfang. Så er du sikker bruger af MS-Office-pakken og har rette laboratorieerfaring, hører vi gerne fra dig.
Der kan evt. også blive tale om opgaver i form af kalibreringer af laboratorieudstyr samt diverse produktionsudstyr jf. kalibreringsinstruktioner, udførelse af allergene analyser samt diverse ad hoc kvalitetskontrol opgaver.
Opret dig i vores database her: https://www.labvikar.dk/bliv-labvikar/
Tjek om du har alt på plads hos LabVikar via https://www.labvikar.dk/tjekliste/ og send derpå et par linjer om dine kompetencer til katja@labvikar.dk under emnet ”Mikrobiologiske analyser i Århusområdet”. Vi holder løbende samtaler.
LabVikar ApS
Avernakøvænget 4
5000 Odense C